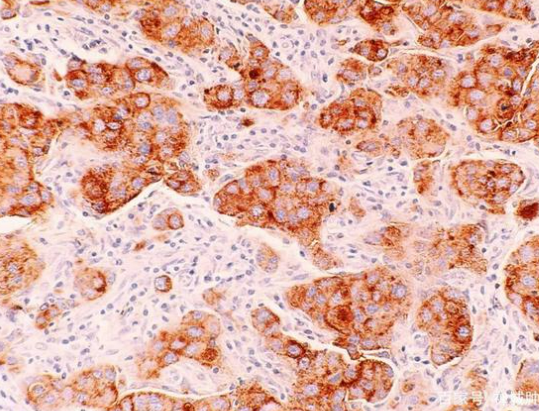

1 病理学诊断分类、分级和分期方案
1.1 组织学分型
参见附录Ⅴ-B,组织学分型主要依据2019版世界卫生组织(World Health Organization,WHO)乳腺肿瘤分类,某些组织学类型的准确区分需行免疫组织化学和(或)分子病理学检测后确定。
1.2 组织学分级
浸润性乳腺癌和DCIS的组织学分级参见附录Ⅴ-C。组织学分级是重要的预后因素。推荐采用Nottingham分级系统对浸润性乳腺癌进行组织学分级。根据腺管形成的比例、细胞的异型性和核分裂象计数三项指标分别独立评估,各给予1~3分,相加后根据总分将浸润性癌分为高、中、低三个级别。

腺管分化程度的评估针对整个肿瘤,需要在低倍镜下评估。只计数有明确中央腺腔且由有极向肿瘤细胞包绕的结构,以腺管/肿瘤区域的百分比表示。细胞核多形性的评估要选取多形性最显著的区域。该项评估参考周围正常乳腺上皮细胞的细胞核大小、形状和核仁大小。当周边缺乏正常细胞时,可用淋巴细胞作为参照。
当细胞核与周围正常上皮细胞的大小和形状相似、染色质均匀分布时,视为1分;当细胞核比正常细胞大,形状和大小有中等程度差异,可见单个核仁时,视为2分;当细胞核的大小有显著差异,核仁显著,可见多个核仁时应视为3分。
只计数明确的核分裂象,不计数核浓染和核碎屑。核分裂象计数区域必须根据显微镜高倍视野的直径进行校正。核分裂象计数要选取增殖最活跃的区域,一般常见于肿瘤边缘,如果存在异质性,要选择核分裂象多的区域。
1.3 乳腺癌的分期
参见AJCC第8版乳腺癌分期系统。包括传统的解剖学分期和预后分期。解剖学分期包括了肿瘤的大小、累及范围(皮肤和胸壁受累情况)、淋巴结转移和远处转移情况。肿瘤大小的测量有多种方法,包括临床体检、影像学评估、病理大体测量和显微镜下测量。乳腺癌分期中涉及到的肿瘤大小是指浸润癌的大小。
由于体检、影像学及大体检查均无法区分浸润性癌和DCIS,因此,显微镜下测量应该是最准确的测量方式。如果浸润性癌范围较大,无法用一个蜡块全部包埋,则以巨检时的肿瘤大小为准。若浸润性癌病灶局限,可以用一个蜡块全部包埋,则肿瘤大小以显微镜下测量的大小为准。

(1)如果肿瘤组织中有浸润性癌和原位癌两种成分,肿瘤的大小应该以浸润性成分的测量值为准。
(2)原位癌伴微浸润:出现微浸润时,应在报告中注明,并测量微浸润灶最大径;如为多灶微浸润,浸润灶大小不能累加,需在报告中注明多灶微浸润,并测量最大浸润灶的最大径。
(3)对于肉眼能确定的发生于同一象限的两个以上多个肿瘤病灶,应在病理学报告中注明为多灶性肿瘤,并分别测量大小,以最大浸润病灶作为分期依据。
(4)对于肉眼能确定的发生于不同象限的两个以上肿瘤病灶,应在病理学检查报告中注明为多中心性肿瘤,并分别测量大小。
(5)如果肿瘤组织完全由DCIS组成,应尽量测量其范围。淋巴结状态是决定乳腺癌患者治疗和预后的重要因素,对于淋巴结转移数位于分期临界值(如1、3和10个转移)附近时,要特别仔细观察淋巴结的转移数目,从而作出准确的pN分期判断。预后分期是在传统解剖学分期基础上增加生物学信息,是解剖学分期的完善和补充。
1.4 免疫组织化学和肿瘤分子病理学检测及其质量控制
(1)应对所有乳腺浸润性癌病例进行雌激素受体(estrogen receptor,ER)、孕激素受体(progesterone receptor,PR)、人表皮生长因子受体2(human epidermal growth factor receptor 2,HER2)免疫组织化学染色,HER2 2+病例应进一步行原位杂交检测。
对DCIS也建议进行ER、PR及HER2免疫组织化学染色。ER、PR的病理学报告需包含阳性细胞强度和百分比。ER、PR检测参考中国《乳腺癌雌、孕激素受体免疫组织化学检测指南(2015版)》(参见附录Ⅴ-D),细胞核ER/PR染色1%~10%定义为“阳性(低表达)”。HER2检测参考中国《乳腺癌HER2检测指南(2019版)》(参见第14章,附录Ⅴ-E)。
(2)应对所有乳腺浸润性癌进行Ki-67增殖指数检测,并对癌细胞中阳性染色细胞所占的百分比进行报告。
(3)PD-L1检测:目前临床研究中采用的PD-L1检测是一套完整的系统,包括所采用的抗体、检测平台和判读系统。常用的PD-L1抗体包括SP142(Ventana)和22C3(DAKO),前者的判读采用免疫细胞评分,后者采用综合阳性评分(CPS评分)。
(4)可进行肿瘤浸润淋巴细胞分级系统对浸润性乳腺癌进行组织学分级。根据腺管形成的比例、细胞的异型性和核分裂象计数三项指标分别独立评估,各给予1~3分,相加后根据总分将浸润性癌分为高、中、低三个级别。腺管分化程度的评估针对整个肿瘤,需要在低倍镜下评估。
(5)开展乳腺癌免疫组织化学和分子病理学检测的实验室应建立完整有效的内部质量控制体系,具有合格资质的病理实验室应满足以下条件:
① 应建立完善的标准操作程序,并严格遵照执行,做好每次检测情况的记录和存档工作。应开展同一组织不同批次染色结果的重复性分析。检测相关的仪器和设备应定期维护、校验。任何操作程序和试剂变化均应重新进行严格的验证。
② 从事乳腺癌免疫组织化学和分子病理学检测的实验技术人员和病理学医师应定期进行必要的培训、资格考核和能力评估。
③ 实验室外部质控可通过参加有关外部质控活动来实现。外部质控的阳性和阴性符合率应达到90%以上。外部质控活动推荐每年参加1~2次。不具备检测条件的单位应妥善地保存好标本,以供具有相关资质的病理实验室进行检测。
1.5 病理报告内容及规范
乳腺浸润性癌的病理报告(参见附录Ⅴ-F)应包括与患者治疗和预后相关的所有内容,如肿瘤大小、组织学类型、组织学分级、有无并存的DCIS、有无淋巴管血管侵犯(lymphovascular invasion,LVI)、切缘和淋巴结情况等,还应包括ER、PR、HER2表达情况及Ki-67增殖指数。
若为治疗后乳腺癌标本,则应对治疗后反应进行病理学评估。DCIS的病理学诊断报告应报告核级别(低、中或高级别)和有无坏死、手术切缘情况以及ER、PR和HER2表达情况。对癌旁良性病变,应明确报告病变名称或类型。
对保乳标本的评价应包括大体检查及显微镜观察中肿瘤距切缘最近处的距离、若切缘阳性,应注明切缘处肿瘤的类型。LVI需要与乳腺癌标本中经常出现的组织收缩引起的腔隙鉴别。相对而言,收缩腔隙在肿瘤组织内更常见,而在肿瘤主体周围寻找LVI更可靠。
参考:《中国抗癌协会乳腺癌诊治指南与规范(2021年版)》
图片:图虫创意
